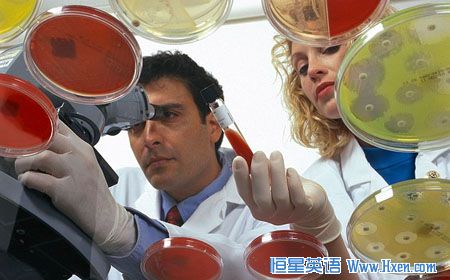

34,000-year-old bacteria have been found inside tiny, fluid-filled chambers within the salt crystals below Death Valley in Eastern California, according to a scientist at the University of Hawaii.
美国夏威夷大学的一名科学家日前称其在加州东部死亡谷地下的盐晶体中充满液体的小细胞中发现了一种细菌,其寿命高达34000岁。
"They're alive, but they're not using any energy, they're not reproducing," said Brian Schubert, who made the discovery. Schubert, who is now an assistant researcher at the University of Hawaii, said the bacteria was shrunken and suspended in a type of hibernation state.
“他们还活着,但是不再消耗能量,也不再繁衍,”这种细菌的发现者舒伯特 布赖恩说道。舒伯特 布赖恩是美国夏威夷大学的助理研究员,他称该种细菌处于萎缩冬眠状态。
The reason for the microbes' astounding life span appears to be due to the fact that they were trapped alongside the algae of a group called Dunaliella. "The most exciting part to me was when we were able to identify the Dunaliella cells in there, because there were hints that could be a food source," he added.
至于该细菌为何会拥有如此惊人的寿命,他认为应该是它们终年生活在“杜氏盐藻”中的原因。“最让我感到兴奋的是我们在该细菌附近发现了杜氏盐藻细胞,因为这意味着盐藻细胞可能是这些细菌的食物来源,”布赖恩补充道。
Tim Lowenstein, a professor in the geology department at Binghamton University says that new research indicates this process can occur in modern saline lake. The new findings are published in the January 2011 edition of GSA Today, the publication of the Geological Society of America.
美国宾厄姆顿大学地质学系的教授蒂姆 罗文斯坦认为,这一新研究表明类似的过程也可能发生在现在的盐水湖中。这些最新的研究成果发表在2011年1月份的美国地质学会的期刊《今日美国地质学会》。
